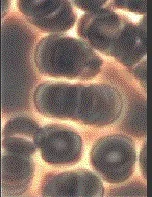

Hyperbaric for Treating Chronic Lyme
Hyperbaric Treatment in Herndon Virginia for Treating Chronic Lyme and many other conditions
Portable Home Hyperbaric Chambers Treat Chronic Lyme
Reprinted from: http://hyperbaricstudies.com/research-studies/portable-home-hyperbaric-chambers-treat-chronic-lyme/
by Hyperbaric Research & Studies
The New Epidemic
Lyme disease is epidemic: it is the fastest growing vector-borne disease in the world. More and more patients are showing up with chronic forms of the infection, leading to multisystemic illness and disability that is devastating to the individuals and families suffering from it. It is increasingly difficult to cure, even with intense regimens of antibiotics. Recent major articles in People Magazine, The Washington Post, and Good Housekeeping describe the debilitating effects of this tricky infection.
Many late-stage Lyme patients improve on antibiotics, but aren’t cured. Many times they don’t get better at all or they relapse every time they stop the antibiotics. Long-term antibiotics can lead to serious side effects, such as fungal infections and immune suppression.
Oxygen to the Rescue?
Hyperbaric oxygen treatment, either alone or in conjunction with antibiotics, has been a mainstay of alternative treatments for lyme for over a decade now. Hyperbaric oxygen forces oxygen into the tissues under pressure, flooding cells and helping to kill organisms and assist the immune system (white blood cells need oxygen in order to kill intruders). Until recently, however, treatment was only available at clinics, which meant that the lyme patient had to travel for treatment, often staying in a motel for weeks or months. The cost was prohibitive. Although profound improvement often resulted, just as many patients slowly relapsed over time, probably due to dormant forms of the bacteria multiplying once treatment ceased. A minimum of 6 weeks and as long as 6 months of daily treatments may be necessary. The cost of treatment, travel, lodging and food at freestanding clinics means that most patients pay around $6,000-8,000 per month of treatment. Most patients do not have the time or money for this.
Now, portable hyperbaric chambers are available to patients for daily use in their homes. These chambers are often called “mild hyperbaric” because they pressurize to 1.3-1.35 ata (between 10 and 11 feet underwater). More and more conditions, from brain trauma to cerebral palsy to chronic infection, are being tested at these “lower” pressures, and they are being found effective. This is causing the hyperbaric industry to go through a sea change in their recommended protocols. Perhaps more is not more. Perhaps less is more.
With portable hyperbaric chambers, there is absolutely no disruption to lifestyle: treatments can be done in the home, at any time of day or night, for as little or long as desired, and the patient can sleep in his or her own bed. Most importantly, treatment can be long-term, which seems to be required for this slow-growing, intracellular, and refractory organism.
Are Home Chambers Effective?
Mild chambers pressurize to about 1.3-1.35 ATA (about 10-11 feet underwater). This is far less than the common protocol used in clinics of 2.5 ata (about 50 feet underwater)—which was established by William Fife in his original experiments on lyme and hyperbaric oxygen. Is 1.3 enough pressure to be effective? We think so. Lyme is a microaerophilic bacterium, one that can survive in small amounts of oxygen. It dies in air, for instance. According to Fife, “a lethal level of oxygen for the spirochete falls somewhere between 30 mm Hg, and 160 mm Hg.” At 1.3ata 90mmHg to 135mmHg will reach the tissues—likely killing at least some lyme. Just as important, the oxygen will help restore the function of hormones and boost immune function, increasing the metabolic efficiency of every cell in the body— which is key in lyme disease, because it so disables the body’s systems. Finally, by adding in other treatments (such as antibiotics, home heat therapies like saunas and peat baths, and herbs, vitamins and minerals), one can attack the lyme steadily and methodically, allowing enough time for the body to heal and gain health, putting lyme in permanent remission.
In fact, 1.3-1.5 ata may be ideal pressures for the body. See the following graph showing oxygen saturation in tissues at varying pressures:
How Does Mild Hyperbaric Oxygen Work?
Lyme disease, like many chronic illnesses, causes a chronic, debilitating dysregulation of the entire immune and nervous system. Patients suffer from simultaneous exhaustion and insomnia, they become sensitive to noise, sound, smells, and light; they react adversely to chemicals; they may even suffer from visual and olfactory hallucinations. All of this may be treated by mild pressure hyperbaric oxygen. According to Ignacio Fojgel, M.D., “The action of pressure and oxygen on the autonomic nervous system has never been given its due attention. I have been insisting that many effects of the chambers are dependent on modification in the autonomic nervous system. Many people sleep during the session or become relaxed and kind of peaceful. Parasympathetic up-regulation, and/or sympathetic down-regulation occur. That is why we sleep during an illness: a relatively high parasympathetic tone is needed for most healing process to happen.”
The Proof is in the Brain and Blood
Mild Hyperbaric oxygen treatments can improve brain function almost immediately, and can improve the appearance of the blood in less than an hour. One remarkable study by Dr. Gunnar Heuser measured brain function by SPECT scan after treatment:
Mild Hyperbaric Therapy As An Immune Modulator
Gunnar Heuser, M.D., Ph.D., Olga Aguilera, M.D., Sylvia Heuser, M.A., Shayna Kasbee, B.A., and Tanya Peach, B.S.
Mild Hyperbaric Oxygen treatment (mHBO) in a portable chamber, at 1.3 ATA and 24% oxygen, administered daily for ten consecutive sessions (1 hour each) improves brain function as measured by SPECT brain scan and a test for attention and reaction time.
Patients often report a sense of well-being and youthfulness after mHBO therapy.
We wondered whether immune function is positively affected by mHBO. We chose apoptosis (a function of programmed cell death) and natural killer cell activity (a function of immune surveillance) as parameters in 9 patients.
Our preliminary data, illustrated in graph form, show that 10 mHBO sessions can positively affect immune function: natural killer cell function increases and apoptosis values decrease. More sessions may be needed to affect positive results in an even higher percentage of patients.
We conclude that mHBO can improve immune function. Since apoptosis numbers increase with age the reversal of that process may have significance with regard to aging.
Clumped red blood cells before mild hyperbaric therapy
Finally, we have included a photo of red blood cells before a 40-minute session in a portable, mild hyperbaric chamber, as well as an after photo. No extra oxygen was used: simply pressurizing with air raises oxygen levels in the air from 21% to 24%, and pushes that extra bit of oxygen more deeply into the plasma. This pictures shows that red blood cells, which tend to clump in chronic illness, unclump after a 40-minute session. When unclumped, more oxygen is available to the system because the entire red blood cell is freely moving through the body.
Unclumped red blood cells after mild hyperbaric session
The Future is Bright
Chronic lyme disease—the fastest growing vector-born epidemic, and one of the most disabling chronic infections facing us today—is gaining national attention. Treatment with Hyperbaric oxygen via home chambers is also a burgeoning area of research, and as more and more doctors and patients experiment with this modality, its profound health benefits will be increasingly recognized, and treatment protocols refined and optimized. These home chambers provide a valuable tool on the road to cure for difficult conditions like lyme disease.